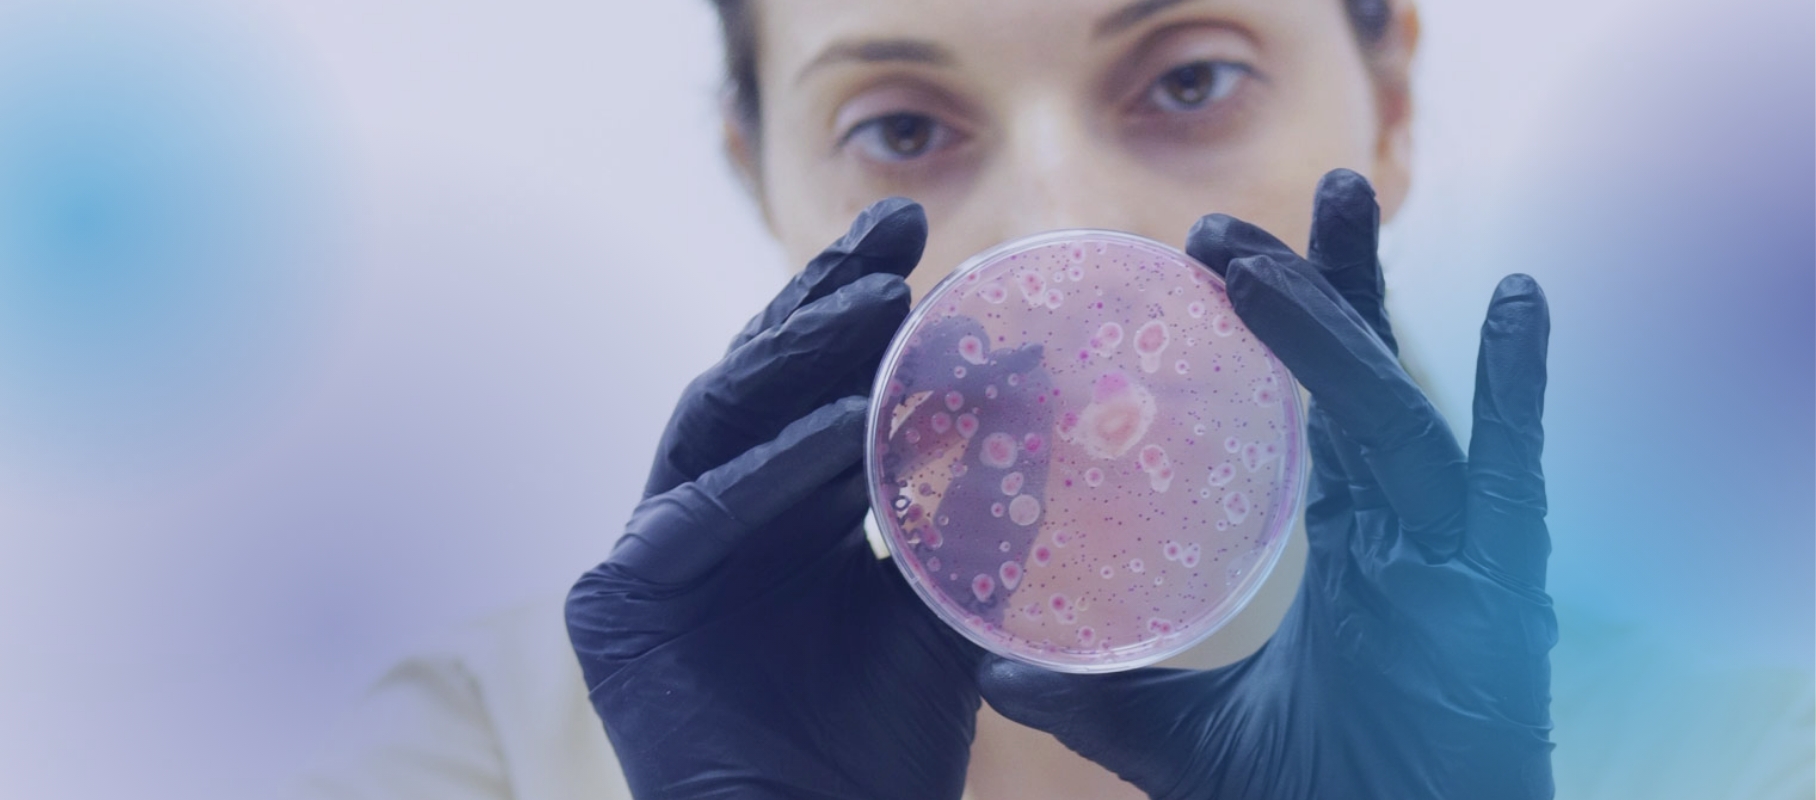
...
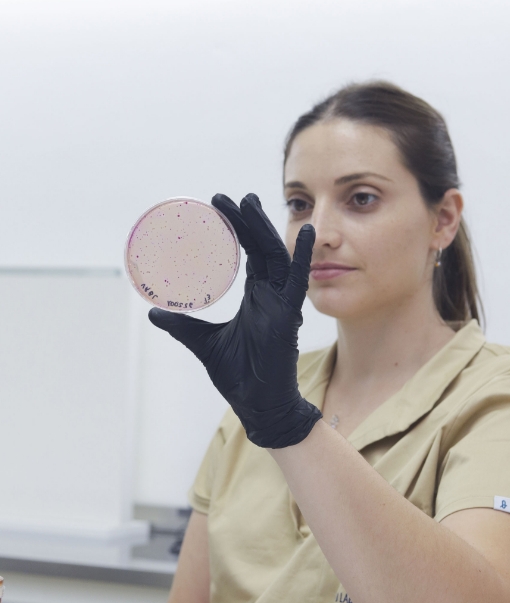

Certezas para cuidar
lo que importa
Ciencia, tecnología y rigurosidad para transformar cada muestra en un resultado confiable.
Conocer más
Resultados que
respaldan decisiones
Detrás de cada resultado hay compromiso con la salud, la producción y el ambiente.
Conocer más
Garantía Sanitaria
para su Producción
- Aujeszky
- Brucelosis
- Anemia infecciosa equina
- Leucosis enzoótica bovina